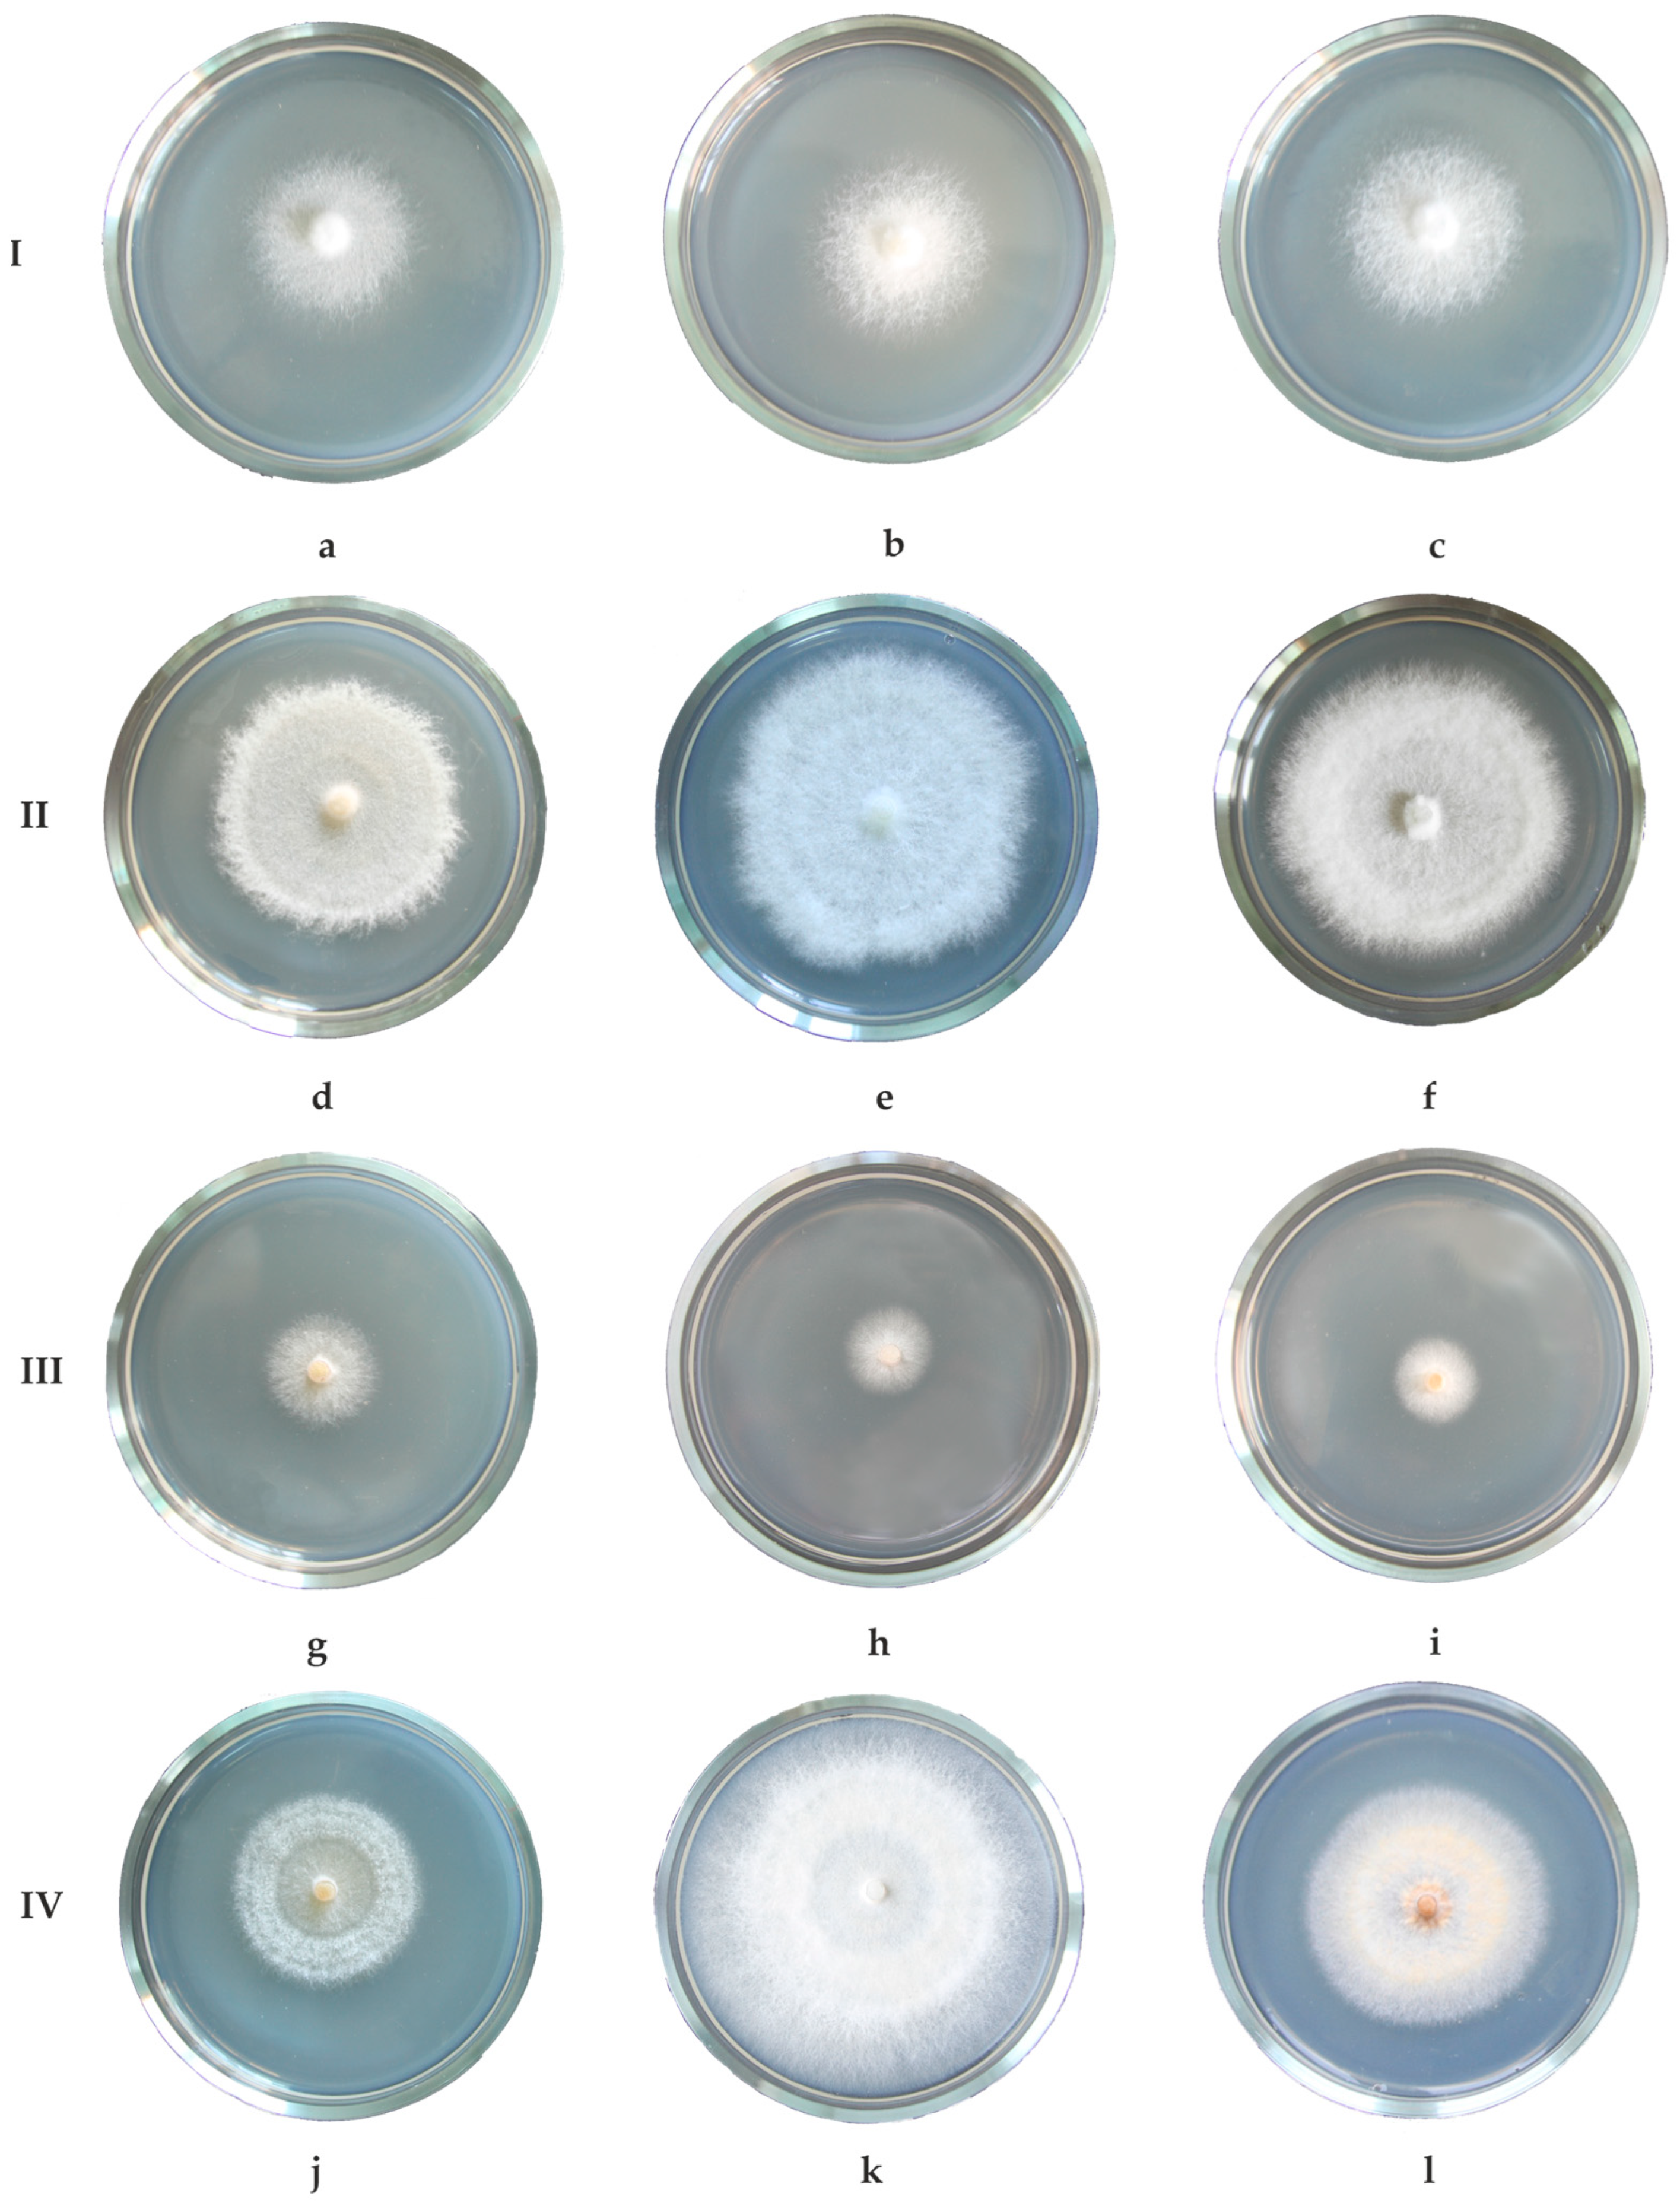

The Specific and Total CO2 Emission Activity of Wood-Decaying Fungi and Their Response to Increases in Temperature
Abstract
1. Introduction
2. Materials and Methods
3. Results
4. Discussion
5. Conclusions
Author Contributions
Funding
Institutional Review Board Statement
Informed Consent Statement
Data Availability Statement
Acknowledgments
Conflicts of Interest
References
- Kudeyarov, V.; Zavarzin, G.; Blagodatskii, S.; Borisov, A.; Voronin, P.Y.; Demkin, V.; Demkina, T.; Evdokimov, I.; Zamolodchikov, D.; Karelin, D.; et al. Pools and Fluxes of Carbon in Terrestrial Ecosystems of Russia; Nauka: Moscow, Russia, 2007. (In Russian) [Google Scholar]
- Wu, J.; Zhang, X.; Wang, H.; Sun, J.; Guan, D. Respiration of Downed Logs in an Old-Growth Temperate Forest in North-Eastern China. Scand. J. For. Res. 2010, 25, 500–506. [Google Scholar] [CrossRef]
- Safonov, S.S.; Karelin, D.V.; Grabar, V.A.; Latyshev, B.A.; Grabovskiy; Uvarova, N.E.; Zamolodchikov, D.G.; Korotkov, V.N.; Gytarsky, M.L. Carbon emissions from the decomposition of dead wood in the southern taiga spruce forest. Russ. J. For. Sci. 2012, 5, 44–49. [Google Scholar]
- Journeaux, K.L.; Boddy, L.; Rowland, L.; Hartley, I.P. A Positive Feedback to Climate Change: The Effect of Temperature on the Respiration of Key Wood-Decomposing Fungi Does Not Decline with Time. Glob. Chang. Biol. 2024, 30, e17212. [Google Scholar] [CrossRef] [PubMed]
- Zavarzin, G.A.; Zavarzina, A.G. Xylotrophic and Mycophilic Bacteria in Formation of Dystrophic Waters. Microbiology 2009, 78, 523–534. [Google Scholar] [CrossRef]
- Rayner, A.D.M.; Boddy, L. Fungal Decomposition of Wood: Its Biology and Ecology; Wiley: Hoboken, NJ, USA, 1988; ISBN 978-0-471-10310-3. [Google Scholar]
- Boddy, L.; Watkinson, S.C. Wood Decomposition, Higher Fungi, and Their Role in Nutrient Redistribution. Botany 1995, 73, 1377–1383. [Google Scholar] [CrossRef]
- Watkinson, S.; Bebber, D.; Darrah, P.; Fricker, M.; Tlalka, M.; Boddy, L. The Role of Wood Decay Fungi in the Carbon and Nitrogen Dynamics of the Forest Floor. In Fungi in Biogeochemical Cycles; Gadd, G.M., Ed.; British Mycological Society Symposia; Cambridge University Press: Cambridge, UK, 2006; pp. 151–181. ISBN 978-0-521-84579-3. [Google Scholar]
- Baldrian, P.; Lindahl, B. Decomposition in Forest Ecosystems: After Decades of Research Still Novel Findings. Fungal Ecol. 2011, 4, 359–361. [Google Scholar] [CrossRef]
- Mukhin, V.A.; Diyarova, D.K. Eco-Physiological Adaptations of the Xylotrophic Basidiomycetes Fungi to CO2 and O2 Mode in the Woody Habitat. J. Fungi 2022, 8, 1296. [Google Scholar] [CrossRef] [PubMed]
- Mukhin, V.A.; Diyarova, D.K.; Gitarskiy, M.L.; Zamolodchikov, D.G. Carbon and Oxygen Gas Exchange in Woody Debris: The Process and Climate-Related Drivers. Forests 2021, 12, 1156. [Google Scholar] [CrossRef]
- Kirschbaum, M.U.F. The Temperature Dependence of Soil Organic Matter Decomposition, and the Effect of Global Warming on Soil Organic C Storage. Soil Biol. Biochem. 1995, 27, 753–760. [Google Scholar] [CrossRef]
- Davidson, E.A.; Janssens, I.A. Temperature Sensitivity of Soil Carbon Decomposition and Feedbacks to Climate Change. Nature 2006, 440, 165–173. [Google Scholar] [CrossRef] [PubMed]
- Soloviev, V.A. Respiratory Gas Exchange of Wood; LGU: Leningrad, Russia, 1987. (In Russian) [Google Scholar]
- Chen, H.; Harmon, M.E.; Griffiths, R.P.; Hicks, W. Effects of Temperature and Moisture on Carbon Respired from Decomposing Woody Roots. For. Ecol. Manag. 2000, 138, 51–64. [Google Scholar] [CrossRef]
- Zhou, L.; Dai, L.; Gu, H.; Zhong, L. Review on the Decomposition and Influence Factors of Coarse Woody Debris in Forest Ecosystem. J. For. Res. 2007, 18, 48–54. [Google Scholar] [CrossRef]
- Olajuyigbe, S.; Tobin, B.; Nieuwenhuis, M. Temperature and Moisture Effects on Respiration Rate of Decomposing Logs in a Sitka Spruce Plantation in Ireland. For. Int. J. For. Res. 2012, 85, 485–496. [Google Scholar] [CrossRef]
- Diyarova, D.K.; Vladykina, V.D.; Mukhin, V.A. Temperature Effect on CO2 Emission by Two Xylotrophic Fungi and by Wood Debris. Russ. J. Ecol. 2023, 54, 213–220. [Google Scholar] [CrossRef]
- Bilay, V.I. (Ed.) Methods of Experimental Mycology; Naukova Dumka: Kyiv, Ukraine, 1982. (In Russian) [Google Scholar]
- Ryvarden, L.; Gilbertson, R.L. European Polypores: Abortiporus–Lindtneria; European Polypores; Fungiflora: Oslo, Norway, 1993; ISBN 978-82-90724-12-7. [Google Scholar]
- Index Fungorum Home Page. Available online: https://www.indexfungorum.org/ (accessed on 28 May 2024).
- Judova, J.; Dubikova, K.; Gaperova, S.; Gaper, J.; Pristas, P. The Occurrence and Rapid Discrimination of Fomes fomentarius Genotypes by ITS-RFLP Analysis. Fungal Biol. 2012, 116, 155–160. [Google Scholar] [CrossRef] [PubMed]
- Peintner, U.; Kuhnert-Finkernagel, R.; Wille, V.; Biasioli, F.; Shiryaev, A.; Perini, C. How to Resolve Cryptic Species of Polypores: An Example in Fomes. IMA Fungus 2019, 10, 17. [Google Scholar] [CrossRef] [PubMed]
- Zhuykova, E.V.; Mukhin, V.A. Diversity and Ecological Features of Phylogenetic Lineages of Tinder Fungus in the Urals. Russ. J. Ecol. 2022, 53, 366–372. [Google Scholar] [CrossRef]

| Temperature, °C | Time | Fomitopsis betulina | Specific Emission, µg CO2/cm2/h | Phellinus igniarius | Specific Emission, µg CO2/cm2/h | ||
|---|---|---|---|---|---|---|---|
| Mycelium Area, cm2 | Total Emission, µg CO2/h | Mycelium Area, cm2 | Total Emission, µg CO2/h | ||||
| 10 | 0 h | 10 ± 0.5 | 182 ± 5.0 | 18 ± 0.8 | 6 ± 0.2 | 168 ± 12.0 | 30 ± 2.8 |
| 24 h | 13 ± 1.4 | 233 ± 1.1 | 19 ± 2.0 | 6 ± 0.2 | 165 ± 47.1 | 30 ± 8.7 | |
| 20 | 0 h | 13 ± 1.4 | 303 ± 69.2 | 25 ± 7.1 | 6 ± 0.2 | 326 ± 21.9 | 56 ± 4.3 |
| 24 h | 21 ± 1.6 | 490 ± 10.2 | 24 ± 2.2 | 9 ± 0.5 | 517 ± 11.2 | 60 ± 4.9 | |
| 25 | 0 h | 21 ± 1.6 | 671 ± 52.5 | 32 ± 2.6 | 9 ± 0.5 | 697 ± 20.1 | 80 ± 2.7 |
| 24 h | 27 ± 3.0 | 789 ± 34.7 | 30 ± 2.6 | 13 ± 0.8 | 988 ± 46.8 | 80 ± 5.2 | |
| 30 | 0 h | 27 ± 3.0 | 1024 ± 56.4 | 40 ± 6.0 | 13 ± 0.8 | 1077 ± 16.9 | 87 ± 7.3 |
| 24 h | 35 ± 3.9 | 1076 ± 87.3 | 33 ± 5.9 | 18 ± 0.6 | 1062 ± 49.6 | 60 ± 4.7 | |
| 35 | 0 h | 35 ± 3.9 | 1049 ± 129.5 | 32 ± 6.8 | 18 ± 0.6 | 946 ± 92.8 | 53 ± 4.2 |
| 24 h | 35 ± 3.1 | 917 ± 27.4 | 27 ± 2.4 | 19 ± 0.5 | 645 ± 24.7 | 35 ± 0.4 | |
| Temperature, °C | Time | Fomitopsis pinicola (Betula) | Specific Emission, µg CO2/cm2/h | Fomitopsis pinicola (Picea) | Specific Emission, µg CO2/cm2/h | ||
|---|---|---|---|---|---|---|---|
| Mycelium Area, cm2 | Total Emission, µg CO2/h | Mycelium Area, cm2 | Total Emission, µg CO2/h | ||||
| 10 | 0 h | 11 ± 1.3 | 244 ± 34.7 | 23 ± 6.0 | 13 ± 0.8 | 242 ± 17.6 | 19 ± 0.5 |
| 24 h | 14 ± 1.3 | 319 ± 20.4 | 23 ± 3.7 | 18 ± 1.2 | 336 ± 22.4 | 19 ± 2.5 | |
| 20 | 0 h | 14 ± 1.3 | 495 ± 22.8 | 35 ± 1.7 | 18 ± 1.2 | 699 ± 44.7 | 40 ± 2.9 |
| 24 h | 18 ± 1.8 | 740 ± 36.9 | 41 ± 4.3 | 21 ± 1.4 | 856 ± 0.6 | 40 ± 2.5 | |
| 25 | 0 h | 18 ± 1.8 | 959 ± 62.3 | 52 ± 2.2 | 21 ± 1.4 | 1072 ± 18.5 | 50 ± 2.7 |
| 24 h | 29 ± 2.3 | 1698 ± 22.0 | 59 ± 4.4 | 27 ± 1.3 | 1416 ± 26.6 | 53 ± 2.3 | |
| 30 | 0 h | 29 ± 2.3 | 2076 ± 13.1 | 73 ± 6.4 | 27 ± 1.3 | 1955 ± 37.7 | 73 ± 2.6 |
| 24 h | 38 ± 2.5 | 2736 ± 44.3 | 73 ± 6.5 | 35 ± 1.4 | 2551 ± 35.0 | 74 ± 3.5 | |
| 35 | 0 h | 38 ± 2.5 | 2771 ± 34.1 | 74 ± 5.7 | 35 ± 1.4 | 2382 ± 49.2 | 69 ± 1.6 |
| 24 h | 42 ± 2.3 | 2670 ± 83.9 | 65 ± 5.2 | 43 ± 0.9 | 2290 ± 33.7 | 53 ± 1.2 | |
| Temperature, °C | Time | Fomes fomentarius | Specific Emission, µg CO2/cm2/h | Fomes inzengae | Specific Emission, µg CO2/cm2/h | ||
|---|---|---|---|---|---|---|---|
| Mycelium Area, cm2 | Total Emission, µg CO2/h | Mycelium Area, cm2 | Total Emission, µg CO2/h | ||||
| 10 | 0 h | 2 ± 0.1 | 116 ± 1.1 | 54 ± 4.7 | 3 ± 0.2 | 141 ± 15.2 | 53 ± 7.8 |
| 24 h | 3 ± 0.1 | 147 ± 17.5 | 55 ± 7.8 | 4 ± 0.5 | 250 ± 42.4 | 69 ± 3.6 | |
| 20 | 0 h | 3 ± 0.1 | 222 ± 36.3 | 83 ± 11.9 | 4 ± 0.5 | 328 ± 75.4 | 92 ± 15.2 |
| 24 h | 6 ± 0.2 | 681 ± 98.0 | 106 ± 11.8 | 5 ± 0.5 | 516 ± 13.7 | 104 ± 7.5 | |
| 25 | 0 h | 6 ± 0.2 | 884 ± 78.6 | 139 ± 12.0 | 5 ± 0.5 | 707 ± 53.2 | 142 ± 7.4 |
| 24 h | 13 ± 0.2 | 2064 ± 133.9 | 154 ± 9.2 | 9 ± 0.7 | 1269 ± 98.9 | 146 ± 2.7 | |
| 30 | 0 h | 13 ± 0.2 | 1878 ± 36.9 | 140 ± 3.0 | 9 ± 0.7 | 1637 ± 56.9 | 190 ± 13.4 |
| 24 h | 19 ± 0.8 | 2401 ± 41.0 | 127 ± 3.0 | 12 ± 0.8 | 1868 ± 26.2 | 155 ± 8.2 | |
| 35 | 0 h | 19 ± 0.8 | 2588 ± 127.5 | 137 ± 1.3 | 12 ± 0.8 | 1777 ± 82.6 | 147 ± 6.6 |
| 24 h | 25 ± 1.3 | 2042 ± 183.5 | 84 ± 10.7 | 16 ± 1.0 | 1650 ± 78.9 | 102 ± 10.5 | |
Disclaimer/Publisher’s Note: The statements, opinions and data contained in all publications are solely those of the individual author(s) and contributor(s) and not of MDPI and/or the editor(s). MDPI and/or the editor(s) disclaim responsibility for any injury to people or property resulting from any ideas, methods, instructions or products referred to in the content. |
© 2024 by the authors. Licensee MDPI, Basel, Switzerland. This article is an open access article distributed under the terms and conditions of the Creative Commons Attribution (CC BY) license (https://creativecommons.org/licenses/by/4.0/).
Share and Cite
Mukhin, V.A.; Diyarova, D.K.; Zhuykova, E.V. The Specific and Total CO2 Emission Activity of Wood-Decaying Fungi and Their Response to Increases in Temperature. J. Fungi 2024, 10, 448. https://doi.org/10.3390/jof10070448
Mukhin VA, Diyarova DK, Zhuykova EV. The Specific and Total CO2 Emission Activity of Wood-Decaying Fungi and Their Response to Increases in Temperature. Journal of Fungi. 2024; 10(7):448. https://doi.org/10.3390/jof10070448
Chicago/Turabian StyleMukhin, Victor A., Daria K. Diyarova, and Elena V. Zhuykova. 2024. "The Specific and Total CO2 Emission Activity of Wood-Decaying Fungi and Their Response to Increases in Temperature" Journal of Fungi 10, no. 7: 448. https://doi.org/10.3390/jof10070448
APA StyleMukhin, V. A., Diyarova, D. K., & Zhuykova, E. V. (2024). The Specific and Total CO2 Emission Activity of Wood-Decaying Fungi and Their Response to Increases in Temperature. Journal of Fungi, 10(7), 448. https://doi.org/10.3390/jof10070448

